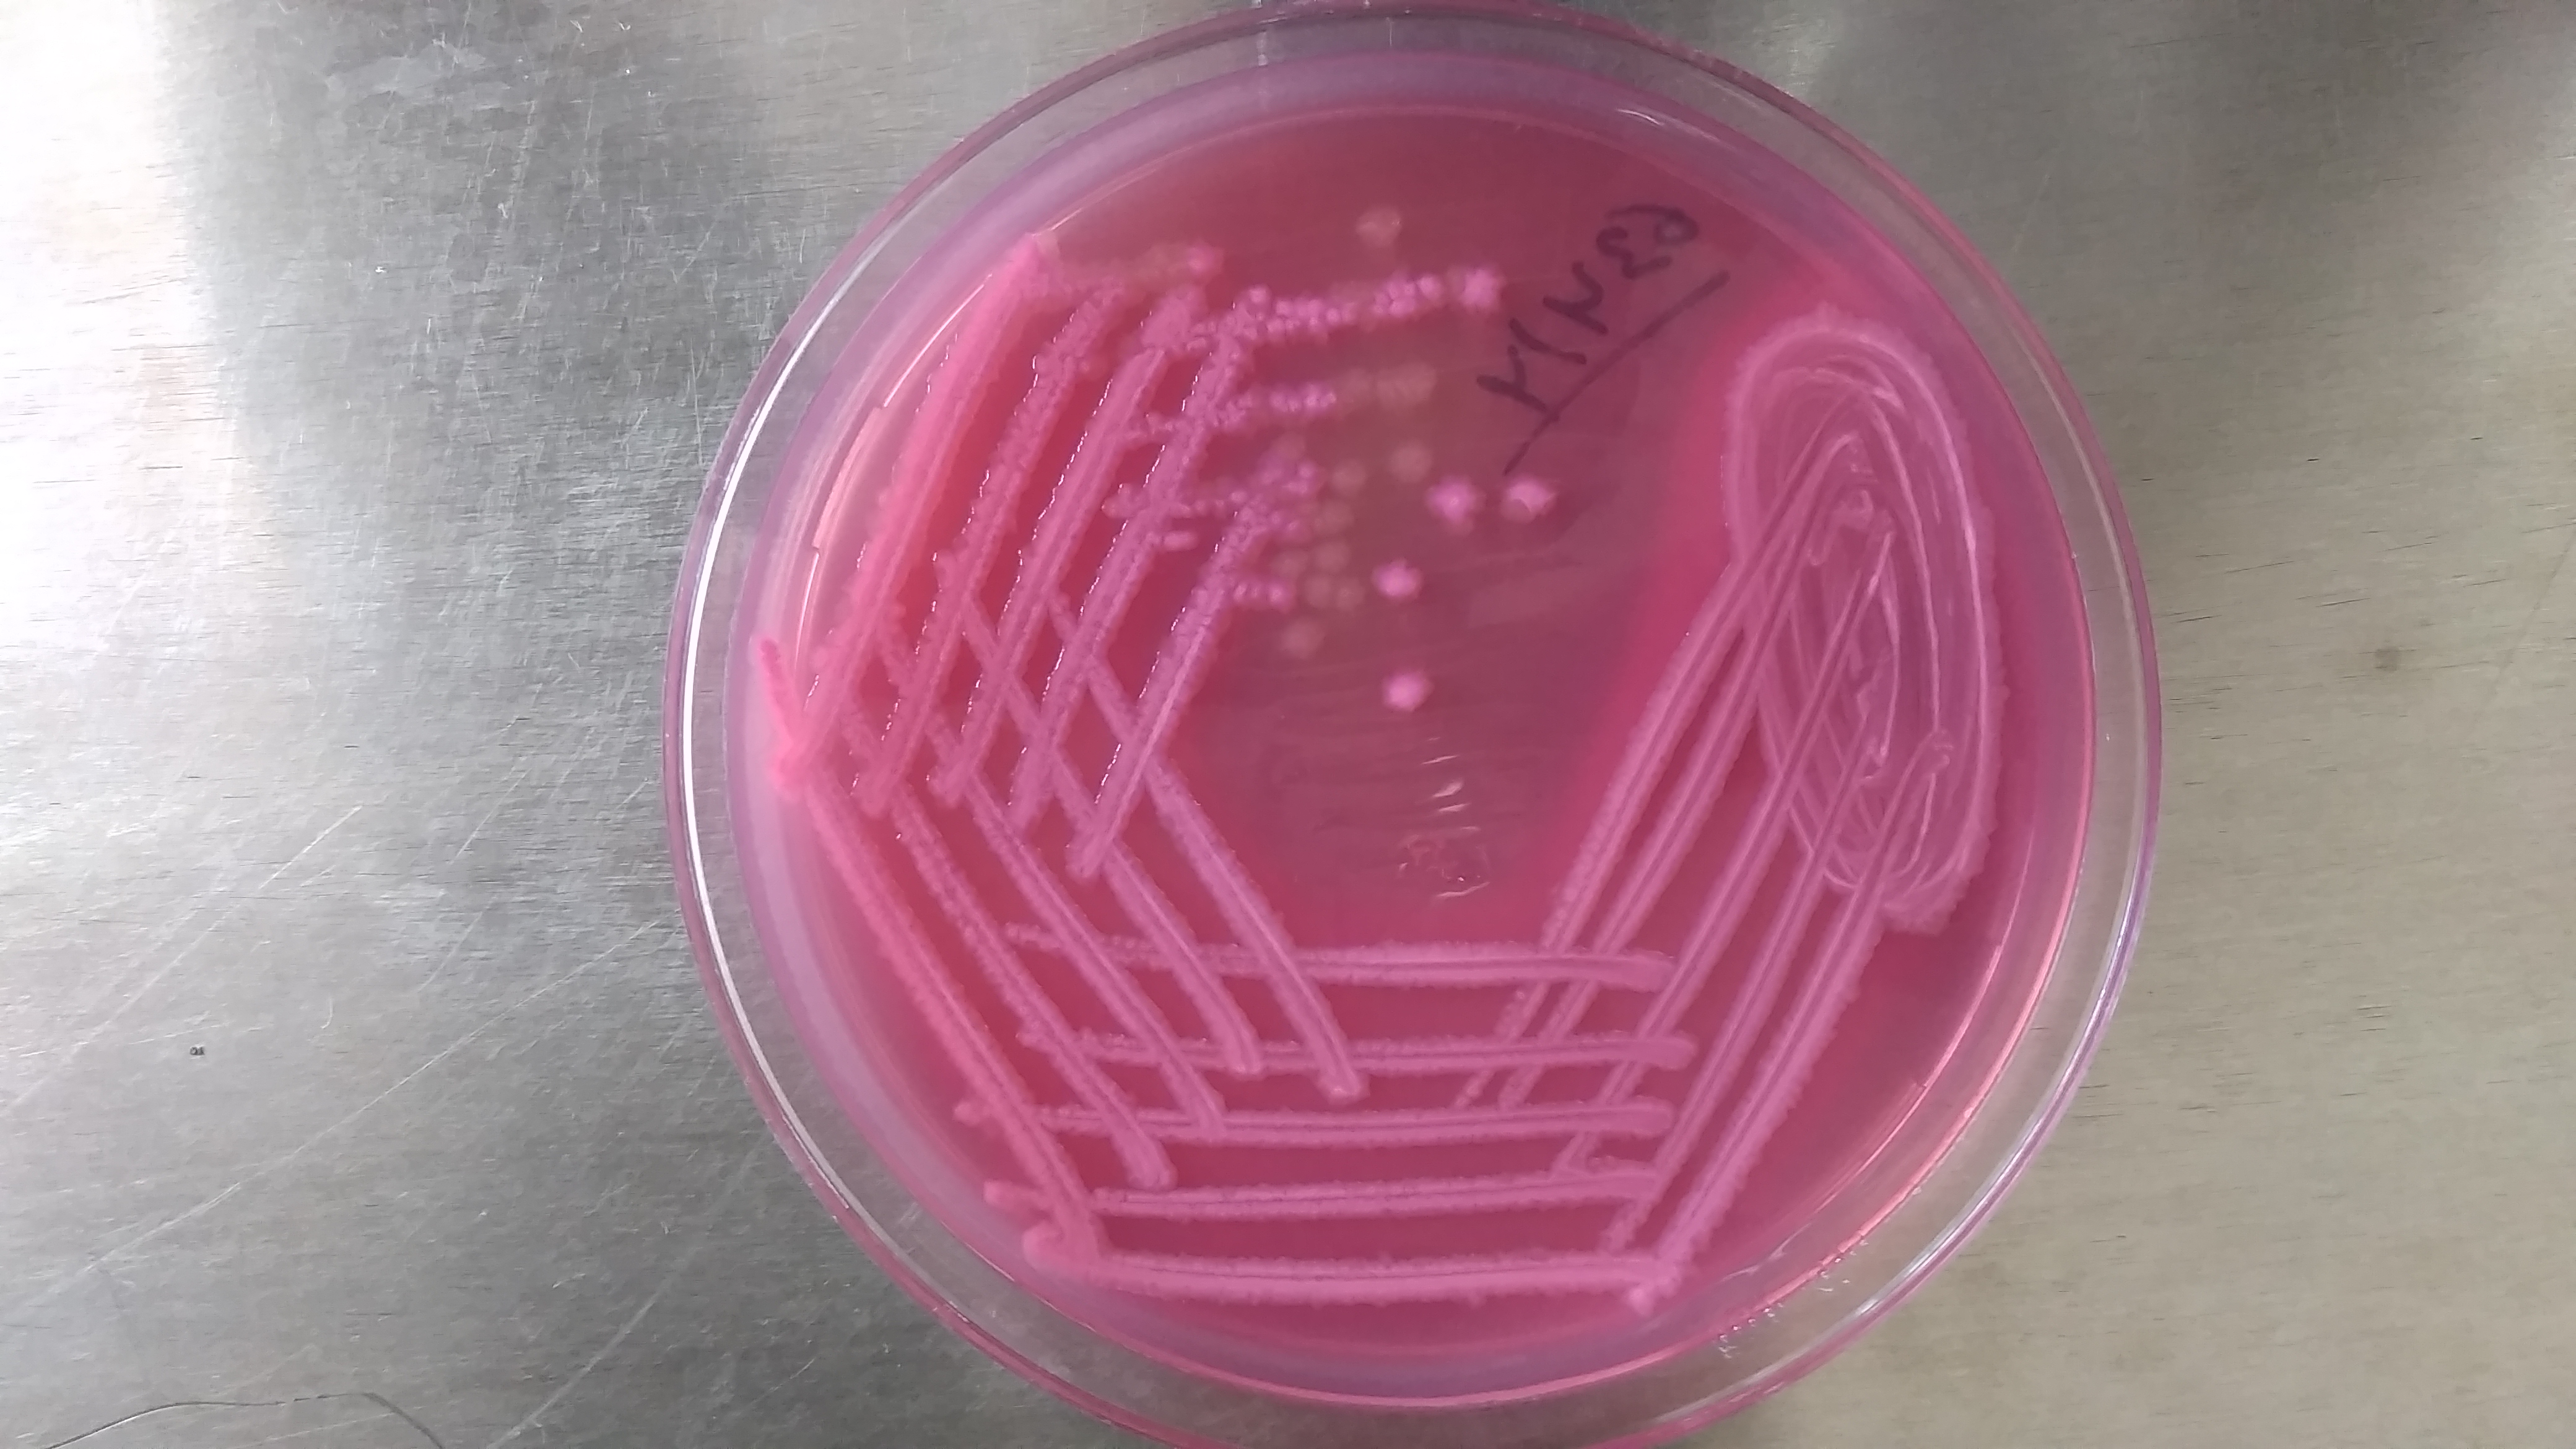

우무
"오늘의AI위키"의 AI를 통해 더욱 풍부하고 폭넓은 지식 경험을 누리세요.
1. 개요
우무는 홍조류에서 추출한 다당류로, 젤리, 푸딩, 미생물 배양 등에 사용되는 물질이다. '아가(agar)'는 말레이어에서 유래되었으며, 일본에서는 '칸텐'으로 불린다. 한천은 17세기 일본에서 토코로텐을 버린 것에서 유래되어 식품 첨가물로 사용되기 시작했다. 이후 미생물 배양 기술의 발달로 수요가 증가했으며, 현재는 다양한 종류로 가공되어 음식, 미생물학, 치의학, 조직병리학 등 여러 분야에서 활용된다. 특히, 젤라틴의 대체재로 사용되며, 다이어트 식품 및 건강 식품의 재료로도 사용된다.
더 읽어볼만한 페이지
2. 역사
"아가(agar)"라는 단어는 한천을 만드는 데 사용되는 홍조류(Gigartina, Eucheuma,[8] Gracilaria)를 가리키는 말레이어 이름인 '''아가-아가(agar-agar)'''에서 유래했다.[9][10] '''한천(Kanten)'''(칸텐/寒天일본어)은 ''칸(kan)'-자라시 토코로텐( 寒曬心太일본어) 또는 "차가운 햇볕에 말린 한천"이라는 구절에서 유래했다. 영어로는 '''일본 이싱글라스(Japanese isinglass)''', '''차이나 그래스(China grass)''', '''실론 이끼(Ceylon moss)''', 또는 '''자프나 이끼(Jaffna moss)'''로도 알려져 있다.[11] Gracilaria edulis 또는 그 동의어인 ''G. lichenoides''는 특히 '''아갈-아갈(agal-agal)''' 또는 '''실론 아가(Ceylon agar)'''로 불린다.[12]
일본에서 한천은 1658년 교토 후시미구의 여관 주인 미노 타로자에몬(}} )이 남은 토코로텐을 버렸다가 겨울밤 추위에 응고되는 것을 발견하면서 식품 첨가물로 사용되기 시작했다.[19] 에도 시대 전기, 야마시로국 기이군 후시미 고가고마치(현: 교토부 교토시 후시미구 고가고마치)에서 여관 "미노야" 주인 미노 타로자에몬[52]이 시마즈 오스미노카미가 묵었을 때 밖에 버린 토코로텐이 얼었다가 낮에 녹은 후 시간이 지나 건어물 상태가 된 것을 발견했다. 이를 황벽산만복사를 창건한 은원 선사에게 시식하게 했더니 정진 요리 재료로 활용할 수 있다고 하여 "한사라시 토코로텐"이라고 명명되었으나, 시간이 지나면서 줄여 '''한천'''으로 불리게 되었다.[53][54]
이후 100년 이상 후시미에서 독점적으로 생산되던 한천은 1781년(안영 10년)에 미노야에서 제조법을 배운 셋쓰국 시마가미군 하라무라(현: 오사카부 다카쓰키시 하라)의 미야타 한페이가 1787년이나 1788년(덴메이 7, 8년) 무렵 제조법을 개량하여 셋쓰 지방에 한천 제조를 넓혔다.[58][59] 1798년(관정 10년)에는 호쿠세쓰 삼군 한천 주식회사가 결성되어 농한기 여업으로 한천 제조가 이루어졌다. 1830년(덴포 원년) 무렵에는 탄바국에도 전파되었고, 시나노국 스와군 아나야마무라(현: 나가노현 카야노시 타마가와)의 고바야시 쿠메자에몬[60]이 1841년~1842년(덴포 12~13년) 무렵에 스와 지방에 한천 제조를 넓혀 각한천으로 자리 잡았다.[61]
1881년(메이지 14년), 로베르트 코흐가 한천 배지(한텐바이치)에 의한 세균 배양법을 개발하면서 한천의 국제적 수요가 증가했다.[20][21][22] 제2차 세계 대전 전에는 일본의 중요한 수출품이었지만, 전쟁 중에는 전략적 의미에서 수출을 금지했다.
일본에서는 현재 나가노현 카야노시, 기후현 에나시(구 야마오카정)에서 가는 한천이, 오사카부 다카쓰키시에서 화과자용 실한천이 만들어지고 있다.[59]
필리핀에서는 ''Gracilaria''(''gulaman'')가 수세기 동안 수확되어 젤리로 만들어 먹어왔다.[14][15][17]
필리핀에서는 ''Gracilaria''(타갈로그어로 ''gulaman'')가 수세기 동안 수확되어 신선하게 또는 햇볕에 말려 젤리로 만들어 먹어왔다.[14][15][17] 가장 오래된 기록은 1754년 예수회 사제 후안 데 노세다와 페드로 데 산루카르가 쓴 ''Vocabulario de la lengua tagala''에서 찾을 수 있는데, 여기서 ''golaman'' 또는 ''gulaman''은 "바다에서 자라는, 젤리 같은 보존식품을 만드는 데 사용되는 약초"로 정의되어 있다.[14][15][17] 구소(''Eucheuma'' 속)에서 추출한 카라기난도 비사야인들이 젤리 같은 질감으로 응고시켜 사용했으며, 이는 1637년경 아우구스티노 수도회 선교사 알론소 데 멘트리다가 쓴 ''Diccionario De La Lengua Bisaya, Hiligueina y Haraia de la isla de Panay y Sugbu y para las demas islas''에 기록되어 있다.[16]
인도네시아 말루쿠 제도의 암본섬에서는 ''Graciliaria''에서 한천을 추출하여 절임이나 소스로 먹는다.[17] 말레이계 사람들도 젤리 해조류를 수세기 동안 채취해 왔으며, 19세기 기록에 따르면 건조된 ''Graciliaria''는 영국령 말레이아에서 중국으로 수출되는 주요 상품 중 하나였다.[17][18] 한천으로 만든 찜질약은 조호르와 싱가포르에서 무릎 관절 부기와 종기에도 사용되었다.[17][18]
해조류는 동남아시아 해안 지역 문화권에서 널리 식용으로 사용되어 왔다.[13][17] 필리핀에서는 ''구라만'' (Gracilaria)을 수세기 동안 수확하여 젤리로 만들어 먹었다.[14][15][17] 인도네시아 말루쿠 제도 암본섬에서는 ''Graciliaria''에서 한천을 추출하여 절임이나 소스로 먹는다.[17] 젤리 해조류는 리아우 제도와 싱가포르 해안가에 사는 말레이계 사람들도 선호하며 채취해 왔다.[17] 19세기 영국령 말레이아에서는 건조된 ''Graciliaria''가 중국으로 수출되는 주요 상품 중 하나였다.[17][18]
19세기 후반부터 한천은 다양한 미생물을 배양하는 고체 배지로 사용되기 시작했다. 1882년 독일 미생물학자 발터 헤세는 로베르트 코흐 연구실에서 그의 아내 패니 헤세의 제안으로 한천을 사용한 배지를 사용했다.[21][22] 한천은 높은 녹는점 때문에 배지가 액화되지 않고 높은 온도에서 미생물을 배양할 수 있어 젤라틴을 대체하는 미생물 배지의 기본 재료가 되었다.[23]
미생물학에서 한천의 새로운 용도가 발견되면서 생산량은 급증했다. 제2차 세계 대전까지 전 세계 한천 생산의 대부분은 일본에 집중되어 있었다.[24] 그러나 제2차 세계 대전 발발로 인해 많은 국가들은 미생물학 연구를 계속하기 위해 국내 한천 산업을 구축해야 했다.[24] 제2차 세계 대전 무렵에는 연간 약 2,500톤의 한천이 생산되었으며,[24] 1970년대 중반까지 전 세계 생산량은 연간 약 1만 톤으로 급증했다.[24] 그 이후로 한천 생산은 불안정하고 때로는 과도하게 이용되는 해조류 개체수 때문에 변동을 거듭하고 있다.[25]
2. 1. 어원
"아가(agar)"라는 단어는 한천을 만드는 데 사용되는 홍조류(Gigartina, Eucheuma,[8] Gracilaria)를 가리키는 말레이어 이름인 '''아가-아가(agar-agar)'''에서 유래했다.[9][10] '''한천(Kanten)'''(칸텐/寒天일본어)은 ''칸(kan)'-자라시 토코로텐( 寒曬心太일본어) 또는 "차가운 햇볕에 말린 한천"이라는 구절에서 유래했다. 영어로는 '''일본 이싱글라스(Japanese isinglass)''', '''차이나 그래스(China grass)''', '''실론 이끼(Ceylon moss)''', 또는 '''자프나 이끼(Jaffna moss)'''로도 알려져 있다.[11] Gracilaria edulis 또는 그 동의어인 ''G. lichenoides''는 특히 '''아갈-아갈(agal-agal)''' 또는 '''실론 아가(Ceylon agar)'''로 불린다.[12]2. 2. 동아시아
일본에서 한천은 1658년 교토 후시미구의 여관 주인 미노 타로자에몬(美濃 太郎左衞門)이 남은 토코로텐을 버렸다가 겨울밤 추위에 응고되는 것을 발견하면서 식품 첨가물로 사용되기 시작했다.[19] 에도 시대 전기, 야마시로국 기이군 후시미 고가고마치(현: 교토부 교토시 후시미구 고가고마치)에서 여관 "미노야" 주인 미노 타로자에몬[52]이 시마즈 오스미노카미가 묵었을 때 밖에 버린 토코로텐이 얼었다가 낮에 녹은 후 시간이 지나 건어물 상태가 된 것을 발견했다. 이를 황벽산만복사를 창건한 은원 선사에게 시식하게 했더니 정진 요리 재료로 활용할 수 있다고 하여 "한사라시 토코로텐"이라고 명명되었으나, 시간이 지나면서 줄여 '''한천'''으로 불리게 되었다.[53][54]이후 100년 이상 후시미에서 독점적으로 생산되던 한천은 1781년(안영 10년)에 미노야에서 제조법을 배운 셋쓰국 시마가미군 하라무라(현: 오사카부 다카쓰키시 하라)의 미야타 한페이가 1787년이나 1788년(덴메이 7, 8년) 무렵 제조법을 개량하여 셋쓰 지방에 한천 제조를 넓혔다.[58][59] 1798년(관정 10년)에는 호쿠세쓰 삼군 한천 주식회사가 결성되어 농한기 여업으로 한천 제조가 이루어졌다. 1830년(덴포 원년) 무렵에는 탄바국에도 전파되었고, 시나노국 스와군 아나야마무라(현: 나가노현 카야노시 타마가와)의 고바야시 쿠메자에몬[60]이 1841년~1842년(덴포 12~13년) 무렵에 스와 지방에 한천 제조를 넓혀 각한천으로 자리 잡았다.[61]
1881년(메이지 14년), 로베르트 코흐가 한천 배지(한텐바이치)에 의한 세균 배양법을 개발하면서 한천의 국제적 수요가 증가했다.[20][21][22] 제2차 세계 대전 전에는 일본의 중요한 수출품이었지만, 전쟁 중에는 전략적 의미에서 수출을 금지했다.
일본에서는 현재 나가노현 카야노시, 기후현 에나시(구 야마오카정)에서 가는 한천이, 오사카부 다카쓰키시에서 화과자용 실한천이 만들어지고 있다.[59]
필리핀에서는 ''Gracilaria''(''gulaman'')가 수세기 동안 수확되어 젤리로 만들어 먹어왔다.[14][15][17]
2. 3. 동남아시아
필리핀에서는 ''Gracilaria''(타갈로그어로 ''gulaman'')가 수세기 동안 수확되어 신선하게 또는 햇볕에 말려 젤리로 만들어 먹어왔다.[14][15][17] 가장 오래된 기록은 1754년 예수회 사제 후안 데 노세다와 페드로 데 산루카르가 쓴 ''Vocabulario de la lengua tagala''에서 찾을 수 있는데, 여기서 ''golaman'' 또는 ''gulaman''은 "바다에서 자라는, 젤리 같은 보존식품을 만드는 데 사용되는 약초"로 정의되어 있다.[14][15][17] 구소(''Eucheuma'' 속)에서 추출한 카라기난도 비사야인들이 젤리 같은 질감으로 응고시켜 사용했으며, 이는 1637년경 아우구스티노 수도회 선교사 알론소 데 멘트리다가 쓴 ''Diccionario De La Lengua Bisaya, Hiligueina y Haraia de la isla de Panay y Sugbu y para las demas islas''에 기록되어 있다.[16]인도네시아 말루쿠 제도의 암본섬에서는 ''Graciliaria''에서 한천을 추출하여 절임이나 소스로 먹는다.[17] 말레이계 사람들도 젤리 해조류를 수세기 동안 채취해 왔으며, 19세기 기록에 따르면 건조된 ''Graciliaria''는 영국령 말레이아에서 중국으로 수출되는 주요 상품 중 하나였다.[17][18] 한천으로 만든 찜질약은 조호르와 싱가포르에서 무릎 관절 부기와 종기에도 사용되었다.[17][18]
2. 4. 기타 지역
해조류는 동남아시아 해안 지역 문화권에서 널리 식용으로 사용되어 왔다.[13][17] 필리핀에서는 ''구라만'' (Gracilaria)을 수세기 동안 수확하여 젤리로 만들어 먹었다.[14][15][17] 인도네시아 말루쿠 제도 암본섬에서는 ''Graciliaria''에서 한천을 추출하여 절임이나 소스로 먹는다.[17] 젤리 해조류는 리아우 제도와 싱가포르 해안가에 사는 말레이계 사람들도 선호하며 채취해 왔다.[17] 19세기 영국령 말레이아에서는 건조된 ''Graciliaria''가 중국으로 수출되는 주요 상품 중 하나였다.[17][18]2. 5. 미생물학에서의 발견
19세기 후반부터 한천은 다양한 미생물을 배양하는 고체 배지로 사용되기 시작했다. 1882년 독일 미생물학자 발터 헤세는 로베르트 코흐 연구실에서 그의 아내 패니 헤세의 제안으로 한천을 사용한 배지를 사용했다.[21][22] 한천은 높은 녹는점 때문에 배지가 액화되지 않고 높은 온도에서 미생물을 배양할 수 있어 젤라틴을 대체하는 미생물 배지의 기본 재료가 되었다.[23]미생물학에서 한천의 새로운 용도가 발견되면서 생산량은 급증했다. 제2차 세계 대전까지 전 세계 한천 생산의 대부분은 일본에 집중되어 있었다.[24] 그러나 제2차 세계 대전 발발로 인해 많은 국가들은 미생물학 연구를 계속하기 위해 국내 한천 산업을 구축해야 했다.[24] 제2차 세계 대전 무렵에는 연간 약 2,500톤의 한천이 생산되었으며,[24] 1970년대 중반까지 전 세계 생산량은 연간 약 1만 톤으로 급증했다.[24] 그 이후로 한천 생산은 불안정하고 때로는 과도하게 이용되는 해조류 개체수 때문에 변동을 거듭하고 있다.[25]
3. 화학적 조성 및 물리적 특성
한천은 두 가지 다당류인 아가로스와 아가로펙틴의 혼합물로 구성되어 있으며, 아가로스가 약 70%, 아가로펙틴이 약 30%를 차지한다.[27] 아가로스는 아가로바이오스의 반복 단위로 구성된 선형 중합체이며, 아가로바이오스는 D-갈락토스와 3,6-무수-L-갈락토피라노스로 이루어진 이당류이다.[28] 아가로펙틴은 소량으로 존재하는 더 작은 분자들의 이질적인 혼합물이며, D-갈락토스와 L-갈락토스의 교대 단위로 구성되어 있고, 황산염, 글루쿠론산, 피루브산과 같은 산성 측쇄로 많이 변형되어 있다.[26][27][28]
한천은 물과 섞이면 약 32–42 °C 이하에서 고형화되어 겔을 형성하는데, 이 온도를 겔화점이라고 한다. 그리고 85 °C 이상에서 녹는데, 이 온도를 녹는점이라고 한다.[29] 이러한 겔화점과 녹는점 사이의 온도 차이는 이력 현상으로 알려져 있다.[30] 이러한 특성은 비교적 높은 온도에서 겔의 안정성을 유지하면서 쉽게 녹는다는 적절한 균형을 제공한다.[31] 많은 과학적 응용 분야에서 인체 체온(37 °C)에 가까운 온도에서 배양하는 것이 필요하기 때문에, 한천은 이 온도에서 녹는 젤라틴과 같은 다른 고형화제보다 더 적합하다.[32]
대부분은 식이섬유( 아가로스와 아가로펙틴 등의 다당류)로 이루어져 있으며, 인간의 소화효소만으로는 분해되지 않는다. 하지만 일부는 위산에 의해 분해되어 아가로올리고당이 되어 흡수되고, 생리적인 작용을 하는 것이 최근 연구되고 있다.
한천의 응고 작용은 다당류에 기인한다. 따라서 파인애플이나 키위 등의 과일에 포함된 프로테아제( 단백질 분해 효소)로도 응고가 '''저해되지 않으며''', 따라서 젤라틴(단백질)으로는 응고할 수 없는 이러한 식재료의 모조 젤리로 이용되고 있다.
4. 제법
4. 1. 전통적인 제법
일본에서는 12월부터 이듬해 2월의 혹한기에 한천을 제조한다.; 원료 해조류의 정제
오고노리 등의 원료 해조류는 모래사장에 펼쳐놓고 때때로 담수를 뿌려 십수일 동안 햇볕에 쬐어 엷은 황색으로 표백한다. 표백된 해조류는 하천물에 담가 부드럽게 한 후 물레방아로 찧어 조개껍질, 모래 등을 제거하고 흐르는 물에 씻어 염분과 색소를 제거한다.
; 배합
다른 해조류를 20%~40% 배합하는데, 이는 원료 해조류가 고가이면서, 이것만으로는 너무 단단하기 때문이다.
; 끓이기
끓는 물에 원료 해조류를 넣고 점질 성분을 용출시키기 위해 황산 또는 아세트산을 소량 첨가하여 약 3시간 끓이고 불을 약하게 하여 섭씨 70~80도를 유지한다. 보통 원료 해조류 12kg당 물 약 4kl, 황산 30g(물로 희석)을 사용한다.
; 여과
삼베 주머니에 넣어 느슨하게 눌러 여과액을 취하고 정치하여 윗물을 제거한다. 찌꺼기는 2차 끓임을 하고 1차 끓임 국물에 섞거나 새로운 원료 해조류의 1차 끓임에 사용한다.
; 응고
윗물을 용기에 옮겨 방냉하여 한천으로 응고시킨다. 각한천의 경우, 약 4cm 각형으로 자른다. 실한천의 경우, 한천 틀로 5mm 각의 선형으로 밀어내고 자리 위에 늘어놓는다.
; 동결
동결장은 주위에 높이 약 1.8m의 방풍벽을 두르고 동서로 말뚝(높이 약 50cm)을 박고 가로목을 걸쳐 그 위에 한천을 늘어놓은 자리를 놓고 추운 밤에 동결시킨다. 각한천은 2밤에 걸쳐 동결 완료되는 것이 최상으로 여겨진다. 혹한으로 인해 1밤에 급격한 동결이 일어나면 한천질과 얼음이 따로 분리되어 형질 불량이 된다. 온난하여 동결에 4~5밤 걸리면 부패하기 쉽고 색깔이 변한다. 실한천은 이러한 어려움이 적다.
; 해동
동결되면 다음날 아침 햇볕에 쬐어 얼음을 녹여 수분을 떨어뜨리고 며칠 더 햇볕에 말려 완성품으로 한다.


4. 2. 공업적인 제법
공업적으로는 균질한 분말 한천이 제조된다.- 한천 성분 추출: 우뭇가사리가 원료인 경우, 염소계 표백제로 표백한 후, 끓여서 추출한다. 오고노리가 원료인 경우, 우뭇가사리 한천처럼 겔 강도를 높이기 위해 수산화나트륨 용액으로 알칼리 처리한 후, 염소계 표백제로 표백하여 끓여서 추출한다. 염소계 표백제를 사용하지 않은 무첨가 제품도 존재한다.
- 여과: 불용물을 제거하기 위해 규조토를 넣고 가압 여과한다.
- 응고: 얕은 풀에 주입하여 방치하고, 식힘으로써 응고물을 얻는다.
- 탈수: 우뭇가사리가 원료인 경우, 응고물을 동결 건조법으로 탈수하고, 또한 열풍 건조기로 수분 10%까지 건조시킨다. 오고노리가 원료인 경우, 유압기로 응고물을 가압함으로써 탈수하고, 마찬가지로 열풍 건조기로 건조시킨다.
- 분쇄: 마지막으로 분쇄기로 분쇄함으로써 분말 한천을 얻는다.
5. 종류
한천은 다양한 형태로 가공되며, 각각 다른 특징과 용도를 가진다.[59][66]
- 분말한천: 고순도로 품질이 균일하며 용해성이 우수하다.
- 플레이크한천: 침전되기 어려워 잘 타지 않으며, 고급 일본과자용으로 사용된다.
- 고형한천: 정량으로 만들어져 계량이 필요 없고 품질이 균일하다.
- 각한천: 물에 불리고 체에 거르는 과정이 필요하며, 품질이 불균일하다. 주로 가정 요리용으로 사용된다.
- 실한천: 각한천과 성질이 유사하지만, 일본과자용으로 다루기 쉽다. 셋쓰 지방(摂津地方)에서 생산되는 셋쓰 실한천(摂津糸寒天)은 고급품으로 간사이(関西)와 서일본의 일본과자 전통 기업들의 수요가 높다.[59][66]
- 아가가루(Agar Powder): "agar"는 "한천"의 영어 번역이지만, 일본에서 "아가가루"는 일반적인 한천과 원료, 특성이 다르다. 톳, 오고노리(오곤) 대신 스기노리, 츠노마타 등의 해조류를 원료로 사용하며, 카라기난을 포함한다. 젤라틴보다 투명도와 광택이 우수하고 거의 무미이며, 젤리와 한천의 중간 식감을 가진다. 냉동 후 해동해도 투명도를 유지한다. 로커스트빈검(콩과 식물 캐롭의 종자 추출물)을 첨가하기도 한다. 팥빙수, 젤리, 푸딩 등 부드러운 식감을 즐기는 제품에 사용된다.

- 연해주 한천: 러시아 연해주에서 안펠티아 해조류를 정제하여 만든다. 새의 젖 등 과자 원료로 사용되는 러시아 연해주 특산품이다.
6. 용도
우무는 음식이나 약 또는 공업용으로 쓴다.[73]
==== 요리 ====
우무는 음식, 약, 공업용으로 쓰인다.[73] 저열량 고탄수화물 특성을 이용하여 다이어트 식품으로 사용되며, 포만감 증진, 대사증후군 개선, 장 운동 활성화 등의 효과가 있다.[38]
한천은 천연 식물성 젤라틴 대체재로,[33][34] 젤리,[36] 푸딩, 커스터드를 만드는 데 사용된다.[37] 끓는 물에 녹인 후 감미료, 향료, 색소, 과일, 채소 등을 첨가하여 디저트나 채소 아스픽을 만들거나, 케이크의 젤리 층 등에 활용한다.[35]
일본 요리에서는 안미츠(あんみつ)나 미즈 요칸의 주재료로 사용된다. 필리핀 요리에서는 굴라만(gulaman) 청량 음료, 부코 판단(buko pandan), 아가 플랑(agar flan), 할로할로(halo-halo) 등의 디저트에 사용된다. 베트남 요리에서는 타크(thạch)라는 젤리 디저트에, 인도와 미얀마 요리에서도 디저트 재료로 사용된다. 대만 버블티에도 한천 젤리가 널리 사용된다.
잼, 마멀레이드의 펙틴 대체재, 수플레와 커스터드 강화제로도 사용되며, 러시아 요리인 ''프티치예 몰로코''(새알 요리)의 젤리화된 커스터드 재료로도 사용된다. 겔 정화를 통해 육수, 소스 등의 액체를 정화하는 데에도 사용된다. 멕시코에는 한천 젤리로 만든 전통 사탕인 ''Dulce de Agar''(한천 사탕)가 있다.
한천은 유기농 식품에서 증점제, 겔화제, 조직제, 보습제, 유화제, 풍미 증강제, 흡수제로 사용되는 허용되는 무기/비합성 첨가물이다.[39] 칼로리가 거의 없고, 장에서 기름과 당분의 흡수를 방해하여 다이어트 식품 및 아가로올리고당을 활용한 건강식품으로도 주목받고 있다.
미쓰두에 넣거나, 우유에 한천 가루를 첨가하여 굳힌 우유한[67] 또는 우유羹[68]은 중화요리의 杏仁豆腐에 자주 사용된다. 이시카와현의 가가 요리 「베로베로」( 도야마현에서는 「별갑」)처럼, 생강이 든 다시 국물에 풀어놓은 계란을 넣어 굳힌 요리가 있다. 겔화제로도 사용되며, 달걀을 사용하지 않는 푸딩(cream caramel )에도 사용된다.
쌀밥에 한천을 첨가하면 쌀밥만 섭취했을 때보다 식후 최대 혈당치와 GI지수가 감소하는 것이 확인되었다.[69]
한천을 사용한 식품으로는 담설, 호사복로, 호박갱, 사이다칸, 수이젠, 니키한텐, 밀크양갱, 우유푸딩, 커피젤리, 멜론젤리, 미스즈아메, 수신현병, 젤리빈, 구룡구 등이 있다.
==== 미생물학 ====
우무는 미생물학에서 세균, 균류 등 미생물 배양에 널리 사용된다.[73] 한천 플레이트(페트리 접시)는 한천과 영양소를 혼합하여 만든 배지로, 미생물 배양 및 관찰에 사용된다. 한천은 대부분의 유기체에게 소화되지 않아 미생물 성장에 영향을 주지 않고 안정적으로 유지된다.[73]
다양한 종류의 한천은 각기 다른 목적에 사용된다. 영양 한천은 비까다로운 미생물 배양에 사용되는 허용성 배지이다. 강화 배지는 까다로운 유기체의 성장에 필요한 영양소가 첨가된 배지이다. 예를 들어, 라이소제니 브로스를 포함하는 루리아 버타니(LB) 한천은 박테리아 성장에 사용되는 영양이 풍부한 배지이다.[40] 2216 해양 브로스(MB) 한천은 비브리오 속과 같은 종속 영양성 해양 박테리아의 성장에 최적화되어 있으며, 테리픽 브로스(TB) 한천은 ''대장균''의 고수율 비선택 배양에 사용된다.[40]
선택적 배지는 특정 박테리아의 성장을 촉진하고 다른 박테리아의 성장을 억제하는 데 사용된다. 예를 들어, 항생제 내성 플라스미드를 가진 박테리아를 선택하는 클로닝 실험에서는 항생제가 첨가된 배지를 사용할 수 있다.[42] 티오황산염 구연산염 담즙염 자당(TCBS) 한천은 자당 대사에 따라 비브리오 종을 구별하는 데 사용되며, MacConkey 한천은 담즙염과 크리스탈 바이올렛을 포함하여 그람 음성 박테리아를 선택적으로 배양하고, pH 지시약 염료를 사용하여 락토스 대사 특성을 보여주는 종을 구별한다.
한천은 미생물 운동성 및 이동성 측정에도 사용된다. 영양 한천 블록 내부에 미생물 샘플을 배양하면 운동성이 있는 종은 젤 전체로 이동하지만, 비운동성 종은 초기 샘플 주입 위치 주변에서만 성장한다.
화학주성 및 화학운동성을 측정하기 위해 아가로스 하 배양 세포 이동 분석법이 사용된다. 이 방법은 세포와 화학 유인 물질 사이에 아가로스 젤 층을 배치하여 농도 기울기를 형성하고, 세포가 중력에 역행하여 기울기를 따라 이동하는 것을 관찰한다.
배양액에 한천을 첨가하여 액체 배지를 고체 배지로 만들 수 있으며, 식물의 조직 배양이나 미생물 배양 시 배지를 고형화하는 데 사용된다. 한천으로 굳힌 배지는 한천 배지라고 불린다.
발터 포크트/Walter Vogt영어는 도롱뇽 알의 세부 염색을 위해 색소액을 한천으로 굳혀 아주 작게 잘라 알 표면에 붙이는 국소 생체 염색법/Fate mapping영어을 개발했다. 식물 호르몬인 옥신 연구에서도 싹 부분을 잘라 한천에 올려놓고 이 한천을 이용하여 성장을 조사한 사례가 있다.
또한 순도가 높은 한천은 핵산의 전기영동(아가로스 겔 전기영동)에도 사용된다.
==== 식물 생물학 ====
연구 등급 한천은 식물 생물학에서 광범위하게 사용되는데, 페트리 접시에서 무균 상태에서 묘목 발아를 허용하는 영양소 및/또는 비타민 혼합물로 선택적으로 보충될 수 있기 때문이다.[43] ''애기장대''에 대한 영양소 및/또는 비타민 보충은 대부분의 실험 조건에서 표준이다. 일반적으로 머래시지 & 스쿠그(MS) 영양소 혼합물과 갬보그 B5 비타민 혼합물이 사용된다. 1.0% 한천/0.44% MS+비타민 dH₂O 용액은 일반적인 성장 온도에서 성장 배지에 적합하다. 한천을 사용할 때, 어떤 성장 배지에서든 한천의 고형화는 pH에 따라 달라지며, 고형화에 대한 최적 범위는 5.4~5.7이다.[43] 일반적으로 이 범위까지 pH를 높이려면 수산화칼륨을 사용해야 한다. 일반적인 지침은 250ml GM당 약 600 μl 0.1M KOH이다. 이 전체 혼합물은 오토클레이브의 액체 사이클을 사용하여 살균할 수 있다.
이 배지는 특정 농도의 식물 호르몬 등을 적용하여 특정 성장 패턴을 유도하는 데 적합하다. 원하는 양의 호르몬을 포함하는 용액을 쉽게 준비하고, 알려진 부피의 GM에 첨가하고, 종종 극성인 호르몬을 용해하는 데 사용되었을 수 있는 용매를 살균하고 증발시키기 위해 오토클레이브할 수 있다. 이 호르몬/GM 용액은 발아되거나 황화된 묘목을 뿌린 페트리 접시 표면에 퍼뜨릴 수 있다. 그러나 이끼 ''꼬리이끼(Physcomitrella patens)''를 사용한 실험은 겔화제(한천 또는 젤라이트(Gelrite))의 선택이 식물 세포 배양의 식물 호르몬 민감도에 영향을 미친다는 것을 보여주었다.[44]
배양액에 한천을 첨가함으로써 액체 배지를 고체 배지로 만들 수 있으며, 식물의 조직 배양이나 미생물 배양 시 배지를 고형화하는 데 사용된다. 한천으로 굳힌 배지는 한천 배지라고 불린다.
는 도롱뇽 알의 세부 염색을 위해 색소액을 한천으로 굳혀 아주 작게 잘라 알 표면에 붙이는 이라는 방법을 개발했다. 식물 호르몬인 옥신 연구에서도, 싹 부분을 잘라 한천에 올려놓고 이 한천을 이용하여 성장을 조사한 사례가 있다. 또한 특히 순도가 높은 것은 핵산의 전기영동(아가로스 겔 전기영동)에도 사용된다.
==== 치의학 ====
치과에서 충치 등으로 손상된 치아의 보철물을 제작할 때, 치아를 본떠 치열을 정밀하게 재현한 석고 모형을 만든다. 이때 사용되는 재료(인상재)는 탄력이 있고 세부적인 부분까지 재현할 수 있어야 하는데, 한천 인상재가 이러한 조건을 충족하는 재료 중 하나이다.[73] 하지만 한천은 치수 안정성이 나빠 수분을 흡수하면 팽창하고, 장시간 공기 중에 방치하면 건조되어 수축하므로, 한천 인상재를 사용하면 신속하게 석고 모형을 제작해야 한다.[73]
==== 조직병리학 ====
한천은 조직 표본, 특히 내시경 생검 표본을 처리하는 과정에서 표본의 방향을 정확하게 맞추고 고정하는 매개체로 사용된다.[45] 이를 통해 조직병리학적 처리가 용이하게 이루어진다.
==== 전기화학 ====
한천은 염다리와 젤 플러그를 만드는 데 사용되어 전기화학에 사용된다.[73] 순도가 높은 한천은 핵산의 아가로스 겔 전기영동에 사용된다.[73]
==== 기타 용도 ====
한천은 여러 용도로 사용된다.[73] 치과에서는 인상재로 사용되며, 조직병리학 처리 과정에서 조직 표본을 고정하는 데 쓰인다.[45] 전기화학에서는 염다리와 젤 플러그를 만드는 데 사용되고, 개미집에서 모래를 대체하는 투명한 물질이자 영양원으로 활용된다. 어린이가 가지고 놀 수 있는 찰흙의 천연 성분으로도 쓰이며, 유기농업에서는 생물 비료 성분으로 사용된다.[46] 면역학에서는 침강 반응의 기질로 사용된다. 과거에는 사진 유제나 은박지 제조, 내식각 등에 사용되기도 했다.[47] 자기 공명 탄성 영상에서 조직의 기계적 특성을 모방하는 용도로도 활용된다.[48]
겔리디움 한천은 주로 배양 배지에, 그라실라리아 한천은 주로 식품에 사용된다. 2016년 일본 기업 AMAM은 한천 기반의 포장 시스템 프로토타입 "Agar Plasticity"를 개발했다.[49][50] 특수촬영 기법으로, 미니어처 촬영에서 해면 표현에 한천을 사용하기도 한다.
6. 1. 요리
우무는 음식, 약, 공업용으로 쓰인다.[73] 저열량 고탄수화물 특성을 이용하여 다이어트 식품으로 사용되며, 포만감 증진, 대사증후군 개선, 장 운동 활성화 등의 효과가 있다.[38]한천은 천연 식물성 젤라틴 대체재로,[33][34] 젤리,[36] 푸딩, 커스터드를 만드는 데 사용된다.[37] 끓는 물에 녹인 후 감미료, 향료, 색소, 과일, 채소 등을 첨가하여 디저트나 채소 아스픽을 만들거나, 케이크의 젤리 층 등에 활용한다.[35]
일본 요리에서는 안미츠(あんみつ)나 미즈 요칸의 주재료로 사용된다. 필리핀 요리에서는 굴라만(gulaman) 청량 음료, 부코 판단(buko pandan), 아가 플랑(agar flan), 할로할로(halo-halo) 등의 디저트에 사용된다. 베트남 요리에서는 타크(thạch)라는 젤리 디저트에, 인도와 미얀마 요리에서도 디저트 재료로 사용된다. 대만 버블티에도 한천 젤리가 널리 사용된다.
잼, 마멀레이드의 펙틴 대체재, 수플레와 커스터드 강화제로도 사용되며, 러시아 요리인 ''프티치예 몰로코''(새알 요리)의 젤리화된 커스터드 재료로도 사용된다. 겔 정화를 통해 육수, 소스 등의 액체를 정화하는 데에도 사용된다. 멕시코에는 한천 젤리로 만든 전통 사탕인 ''Dulce de Agar''(한천 사탕)가 있다.
한천은 유기농 식품에서 증점제, 겔화제, 조직제, 보습제, 유화제, 풍미 증강제, 흡수제로 사용되는 허용되는 무기/비합성 첨가물이다.[39] 칼로리가 거의 없고, 장에서 기름과 당분의 흡수를 방해하여 다이어트 식품 및 아가로올리고당을 활용한 건강식품으로도 주목받고 있다.
미쓰두에 넣거나, 우유에 한천 가루를 첨가하여 굳힌 우유한[67] 또는 우유羹[68]은 중화요리의 杏仁豆腐에 자주 사용된다. 이시카와현의 가가 요리 「베로베로」( 도야마현에서는 「별갑」)처럼, 생강이 든 다시 국물에 풀어놓은 계란을 넣어 굳힌 요리가 있다. 겔화제로도 사용되며, 달걀을 사용하지 않는 푸딩(cream caramel )에도 사용된다.
쌀밥에 한천을 첨가하면 쌀밥만 섭취했을 때보다 식후 최대 혈당치와 GI지수가 감소하는 것이 확인되었다.[69]
한천을 사용한 식품으로는 담설, 호사복로, 호박갱, 사이다칸, 수이젠, 니키한텐, 밀크양갱, 우유푸딩, 커피젤리, 멜론젤리, 미스즈아메, 수신현병, 젤리빈, 구룡구 등이 있다.
6. 2. 미생물학
우무는 미생물학에서 세균, 균류 등 미생물 배양에 널리 사용된다.[73] 한천 플레이트(페트리 접시)는 한천과 영양소를 혼합하여 만든 배지로, 미생물 배양 및 관찰에 사용된다. 한천은 대부분의 유기체에게 소화되지 않아 미생물 성장에 영향을 주지 않고 안정적으로 유지된다.[73]
다양한 종류의 한천은 각기 다른 목적에 사용된다. 영양 한천은 비까다로운 미생물 배양에 사용되는 허용성 배지이다. 강화 배지는 까다로운 유기체의 성장에 필요한 영양소가 첨가된 배지이다. 예를 들어, 라이소제니 브로스를 포함하는 루리아 버타니(LB) 한천은 박테리아 성장에 사용되는 영양이 풍부한 배지이다.[40] 2216 해양 브로스(MB) 한천은 비브리오 속과 같은 종속 영양성 해양 박테리아의 성장에 최적화되어 있으며, 테리픽 브로스(TB) 한천은 ''대장균''의 고수율 비선택 배양에 사용된다.[40]
선택적 배지는 특정 박테리아의 성장을 촉진하고 다른 박테리아의 성장을 억제하는 데 사용된다. 예를 들어, 항생제 내성 플라스미드를 가진 박테리아를 선택하는 클로닝 실험에서는 항생제가 첨가된 배지를 사용할 수 있다.[42] 티오황산염 구연산염 담즙염 자당(TCBS) 한천은 자당 대사에 따라 비브리오 종을 구별하는 데 사용되며, MacConkey 한천은 담즙염과 크리스탈 바이올렛을 포함하여 그람 음성 박테리아를 선택적으로 배양하고, pH 지시약 염료를 사용하여 락토스 대사 특성을 보여주는 종을 구별한다.
한천은 미생물 운동성 및 이동성 측정에도 사용된다. 영양 한천 블록 내부에 미생물 샘플을 배양하면 운동성이 있는 종은 젤 전체로 이동하지만, 비운동성 종은 초기 샘플 주입 위치 주변에서만 성장한다.
화학주성 및 화학운동성을 측정하기 위해 아가로스 하 배양 세포 이동 분석법이 사용된다. 이 방법은 세포와 화학 유인 물질 사이에 아가로스 젤 층을 배치하여 농도 기울기를 형성하고, 세포가 중력에 역행하여 기울기를 따라 이동하는 것을 관찰한다.
배양액에 한천을 첨가하여 액체 배지를 고체 배지로 만들 수 있으며, 식물의 조직 배양이나 미생물 배양 시 배지를 고형화하는 데 사용된다. 한천으로 굳힌 배지는 한천 배지라고 불린다.
발터 포크트/Walter Vogt영어는 도롱뇽 알의 세부 염색을 위해 색소액을 한천으로 굳혀 아주 작게 잘라 알 표면에 붙이는 국소 생체 염색법/Fate mapping영어을 개발했다. 식물 호르몬인 옥신 연구에서도 싹 부분을 잘라 한천에 올려놓고 이 한천을 이용하여 성장을 조사한 사례가 있다.
또한 순도가 높은 한천은 핵산의 전기영동(아가로스 겔 전기영동)에도 사용된다.
6. 3. 식물 생물학
연구 등급 한천은 식물 생물학에서 광범위하게 사용되는데, 페트리 접시에서 무균 상태에서 묘목 발아를 허용하는 영양소 및/또는 비타민 혼합물로 선택적으로 보충될 수 있기 때문이다.[43] ''애기장대''에 대한 영양소 및/또는 비타민 보충은 대부분의 실험 조건에서 표준이다. 일반적으로 머래시지 & 스쿠그(MS) 영양소 혼합물과 갬보그 B5 비타민 혼합물이 사용된다. 1.0% 한천/0.44% MS+비타민 dH₂O 용액은 일반적인 성장 온도에서 성장 배지에 적합하다. 한천을 사용할 때, 어떤 성장 배지에서든 한천의 고형화는 pH에 따라 달라지며, 고형화에 대한 최적 범위는 5.4~5.7이다.[43] 일반적으로 이 범위까지 pH를 높이려면 수산화칼륨을 사용해야 한다. 일반적인 지침은 250ml GM당 약 600 μl 0.1M KOH이다. 이 전체 혼합물은 오토클레이브의 액체 사이클을 사용하여 살균할 수 있다.이 배지는 특정 농도의 식물 호르몬 등을 적용하여 특정 성장 패턴을 유도하는 데 적합하다. 원하는 양의 호르몬을 포함하는 용액을 쉽게 준비하고, 알려진 부피의 GM에 첨가하고, 종종 극성인 호르몬을 용해하는 데 사용되었을 수 있는 용매를 살균하고 증발시키기 위해 오토클레이브할 수 있다. 이 호르몬/GM 용액은 발아되거나 황화된 묘목을 뿌린 페트리 접시 표면에 퍼뜨릴 수 있다. 그러나 이끼 ''꼬리이끼(Physcomitrella patens)''를 사용한 실험은 겔화제(한천 또는 젤라이트(Gelrite))의 선택이 식물 세포 배양의 식물 호르몬 민감도에 영향을 미친다는 것을 보여주었다.[44]
배양액에 한천을 첨가함으로써 액체 배지를 고체 배지로 만들 수 있으며, 식물의 조직 배양이나 미생물 배양 시 배지를 고형화하는 데 사용된다. 한천으로 굳힌 배지는 한천 배지라고 불린다.
는 도롱뇽 알의 세부 염색을 위해 색소액을 한천으로 굳혀 아주 작게 잘라 알 표면에 붙이는 이라는 방법을 개발했다. 식물 호르몬인 옥신 연구에서도, 싹 부분을 잘라 한천에 올려놓고 이 한천을 이용하여 성장을 조사한 사례가 있다. 또한 특히 순도가 높은 것은 핵산의 전기영동(아가로스 겔 전기영동)에도 사용된다.
6. 4. 치의학
치과에서 충치 등으로 손상된 치아의 보철물을 제작할 때, 치아를 본떠 치열을 정밀하게 재현한 석고 모형을 만든다. 이때 사용되는 재료(인상재)는 탄력이 있고 세부적인 부분까지 재현할 수 있어야 하는데, 한천 인상재가 이러한 조건을 충족하는 재료 중 하나이다.[73] 하지만 한천은 치수 안정성이 나빠 수분을 흡수하면 팽창하고, 장시간 공기 중에 방치하면 건조되어 수축하므로, 한천 인상재를 사용하면 신속하게 석고 모형을 제작해야 한다.[73]6. 5. 조직병리학
한천은 조직 표본, 특히 내시경 생검 표본을 처리하는 과정에서 표본의 방향을 정확하게 맞추고 고정하는 매개체로 사용된다.[45] 이를 통해 조직병리학적 처리가 용이하게 이루어진다.6. 6. 전기화학
한천은 염다리와 젤 플러그를 만드는 데 사용되어 전기화학에 사용된다.[73] 순도가 높은 한천은 핵산의 아가로스 겔 전기영동에 사용된다.[73]6. 7. 기타 용도
한천은 여러 용도로 사용된다.[73] 치과에서는 인상재로 사용되며, 조직병리학 처리 과정에서 조직 표본을 고정하는 데 쓰인다.[45] 전기화학에서는 염다리와 젤 플러그를 만드는 데 사용되고, 개미집에서 모래를 대체하는 투명한 물질이자 영양원으로 활용된다. 어린이가 가지고 놀 수 있는 찰흙의 천연 성분으로도 쓰이며, 유기농업에서는 생물 비료 성분으로 사용된다.[46] 면역학에서는 침강 반응의 기질로 사용된다. 과거에는 사진 유제나 은박지 제조, 내식각 등에 사용되기도 했다.[47] 자기 공명 탄성 영상에서 조직의 기계적 특성을 모방하는 용도로도 활용된다.[48]겔리디움 한천은 주로 배양 배지에, 그라실라리아 한천은 주로 식품에 사용된다. 2016년 일본 기업 AMAM은 한천 기반의 포장 시스템 프로토타입 "Agar Plasticity"를 개발했다.[49][50] 특수촬영 기법으로, 미니어처 촬영에서 해면 표현에 한천을 사용하기도 한다.
참조
[1]
웹사이트
Agar
http://www.tokyofoun[...]
2016-12-19
[2]
서적
Oxford Dictionary of English
[3]
서적
Handbook of hydrocolloids
https://books.google[...]
Woodhead
[4]
서적
Cyclopædia of India and of eastern and southern Asia, commercial, industrial and scientific: products of the mineral, vegetable and animal kingdoms, useful arts and manufactures
https://archive.org/[...]
Scottish and Adelphi Presses
[5]
서적
The Oxford Companion to Food
https://books.google[...]
Oxford University Press
2006
[6]
웹사이트
Showing Food Agar
https://foodb.ca/foo[...]
[7]
서적
Cyclopaedia of India and of Eastern and Southern Asia, commercial, industrial and scientific...
https://archive.org/[...]
printed at the Scottish Press
[8]
서적
Seaweeds and their Uses
Springer Netherlands
1980
[9]
서적
The cyclopædia of India and of eastern and southern Asia: commercial, industrial and scientific, products of the mineral, vegetable, and animal kingdoms, useful arts and manufactures
https://archive.org/[...]
B. Quaritch
[10]
백과사전
agar
https://nla.gov.au/n[...]
Salavopoulos & Kinderlis
1932
[11]
웹사이트
Agar-Agar
http://www.agar-agar[...]
[12]
웹사이트
Agar-Agar
http://www.botanical[...]
Botanical.com
[13]
서적
Encyclopedia of Modern Coral Reefs: Structure, Form and Process
https://books.google[...]
Springer Science & Business Media
[14]
학술지
Possibilities of Gulaman Dagat as a Substitute for Gelatin in Food
1916
[15]
서적
Vocabulario de la lengua Tagala
Imprenta de la compañia de Jesus
1754
[16]
서적
Diccionario De La Lengua Bisaya, Hiligueina Y Haraya de la isla de Panay
En La Imprenta De D. Manuel Y De D. Felis Dayot
1841
[17]
학술지
The Utilization of Marine Algae in Tropical South and East Asia
https://www.jstor.or[...]
1959
[18]
잡지
The Role of Foraging in Malay Cuisine
https://biblioasia.n[...]
National Library Board, Singapore
2021-10-01
[19]
서적
Difco & BBL Manual
http://www.bd.com/ds[...]
Becton Dickinson and Company
[20]
간행물
Sur la gélose et le nids de salangane (On agar and swiftlet nests)
http://gallica.bnf.f[...]
1859
[21]
간행물
Die Aetiologie der Tuberculose (The etiology of tuberculosis)
http://babel.hathitr[...]
1882-04-10
[22]
잡지
History of the Agar Plate
http://www.labnews.c[...]
2005-11-01
[23]
학술지
Walther and Angelina Hesse–Early Contributors to Bacteriology
http://www.asm.org/c[...]
[24]
서적
The Biology of Seaweeds
https://books.google[...]
University of California Press
[25]
학술지
Lab staple agar hit by seaweed shortage
Nature News
2015-12-08
[26]
웹사이트
Agar
https://water.lsbu.a[...]
[27]
서적
Training manual on Gracilaria culture and seaweed processing in China
Food and Agriculture Organization, United Nations
1990-08-01
[28]
서적
Production and Utilization of Products from Commercial Seaweeds
Food and Agriculture Organization, United Nations
1987
[29]
웹사이트
Agar and Its Use in Chemistry and Science
https://www.scienceb[...]
2008
[30]
웹사이트
Hispanagar {{!}} Hysteresis, what is this peculiar word?
https://www.hispanag[...]
[31]
학술지
Progress in the development of gelling agents for improved culturability of microorganisms
2015-07-23
[32]
웹사이트
Agar-Agar : Definition, Producing and Uses
https://microbiologi[...]
[33]
서적
The Advantages of Being a Vegetarian: Selected Tips
[34]
서적
Plant-Based Made Easy: The Complete Practical Guide to Transitioning to Healthy Whole Food Diet
Nutriplanet (Swing & Step OU)
[35]
서적
Cook's Encyclopaedia
Grub Street Publishing
[36]
서적
Home Economics S2 Tb (nt)
Longman
[37]
서적
Handbook fo Fillers, Extenders, and Diluents
Synapse Information Resources
[38]
학술지
Constipation is a Crime
Lowrey-Marden
1921
[39]
웹사이트
Agar-agar Review Sheet
http://www.ams.usda.[...]
USDA Organic Materials Review
1995-04-01 # Assuming April 1995 refers to the month
[40]
학술지
LB agar
http://cshprotocols.[...]
2009-03-01
[41]
서적
Chapter 7 – Cloning Genes for Synthetic Biology
https://www.scienced[...]
Academic Cell
2022-12-12
[42]
웹사이트
Why Differential & Selective Media Remain Invaluable Tools
https://asm.org/Arti[...]
2020-09-25
[43]
서적
Handbook of marine macroalgae : biotechnology and applied phycology
John Wiley & Sons Inc.
2011
[44]
학술지
Gelrite and agar differently influence cytokinin-sensitivity of a moss
[45]
학술지
Improvised double-embedding technique of minute biopsies: A mega boon to histopathology laboratory
https://www.research[...]
2015-02-01 # Assuming February 2015 refers to the month
[46]
서적
Integrated Organic Farming Handbook
https://books.google[...]
Asia Pacific Business Press Inc.
2013-10-04
[47]
학술지
Black-and-White Photographic Chemistry
https://ntrs.nasa.go[...]
1986-06-01 # Assuming June 1986 refers to the month
[48]
학술지
Reliable preparation of agarose phantoms for use in quantitative magnetic resonance elastography
2019-09-01 # Assuming September 2019 refers to the month
[49]
웹사이트
New Seaweed-Based Material Could Replace Plastic Packaging
https://www.good.is/[...]
2016-03-09
[50]
웹사이트
Design Looks Ahead
http://www.fastcompa[...]
2016-01-26
[51]
서적
マギー キッチンサイエンス
共立出版
2008-10-01 # Assuming October 2008 refers to the month
[52]
웹사이트
美濃屋太郎左衛門(みのや・たろうざえもん)とは? 意味や使い方
https://kotobank.jp/[...]
[53]
웹사이트
御菓子司 亀屋芳邦 「和菓子用語集」
https://www.kameya-y[...]
[54]
웹사이트
寒天の基礎知識
http://www.kanemata.[...]
カネマタ食品工業株式会社
[55]
학술지
寒天の起源についての一考察
日本風俗史学会
1977-03-01 # Assuming March 1977 refers to the month
[56]
학술지
寒天について一考察
虎屋
2013-03-01 # Assuming March 2013 refers to the month
[57]
서적
ようかん
新潮社
2019-10-01 # Assuming October 2019 refers to the month
[58]
웹사이트
株式会社タニチ(寒天の由来・歴史)
http://www.tanichi.j[...]
[59]
보도자료
江戸時代から続く高槻市の伝統産業「寒天」の生産が最盛期
https://prtimes.jp/m[...]
高槻市
2024-02-08
[60]
웹사이트
コトバンクデジタル版 日本人名大辞典+Plus 小林粂左衛門とは
https://kotobank.jp/[...]
[61]
서적
信州寒天業発達史
銀河書房
1993-03-01 # Assuming March 1993 refers to the month
[62]
웹사이트
茅野市の地場産業~天然角寒天~
https://www.city.chi[...]
茅野市ホームページ
[63]
서적
和菓子原材料展「寒天ものがたり」
虎屋 虎屋文庫
1999-05-01 # Assuming May 1999 refers to the month
[64]
웹사이트
寒天のこといろいろ 江戸時代の寒天菓子
http://www.taiyoo.co[...]
株式会社太洋
[65]
웹사이트
山岡町:多くの山に囲まれ、朝晩の寒暖の差が大きいことから寒天の生産で有名
https://www.kankou-e[...]
え~な恵那(恵那市公式観光サイト)
[66]
웹사이트
寒天特集:摂津糸寒天、和菓子向け中心
https://news.nissyok[...]
2000-06-28
[67]
웹사이트
黒豆ゼリー
https://recipe.kirin[...]
KIRINおつまみ道場
[68]
웹사이트
いちご牛乳羹
http://www3.mizkan.c[...]
みつかん Cooking Box
[69]
학술지
米飯の熱特性,感覚特性とグリセミックインデックスに及ぼす寒天の影響
日本調理科学会
2012-04-05
[70]
웹사이트
天寄せ 長野県
https://www.maff.go.[...]
農林水産省
[71]
웹사이트
信州諏訪地方の民謡『天屋節』
https://m.youtube.co[...]
2022-10-17
[72]
뉴스
テレビ朝日 - 食彩の王国 - 2011年2月12日 364回『寒天』
https://www.tv-asahi[...]
[73]
웹인용
우무
https://stdict.korea[...]
국립국어원
2017-12-08
본 사이트는 AI가 위키백과와 뉴스 기사,정부 간행물,학술 논문등을 바탕으로 정보를 가공하여 제공하는 백과사전형 서비스입니다.
모든 문서는 AI에 의해 자동 생성되며, CC BY-SA 4.0 라이선스에 따라 이용할 수 있습니다.
하지만, 위키백과나 뉴스 기사 자체에 오류, 부정확한 정보, 또는 가짜 뉴스가 포함될 수 있으며, AI는 이러한 내용을 완벽하게 걸러내지 못할 수 있습니다.
따라서 제공되는 정보에 일부 오류나 편향이 있을 수 있으므로, 중요한 정보는 반드시 다른 출처를 통해 교차 검증하시기 바랍니다.
문의하기 : help@durumis.com